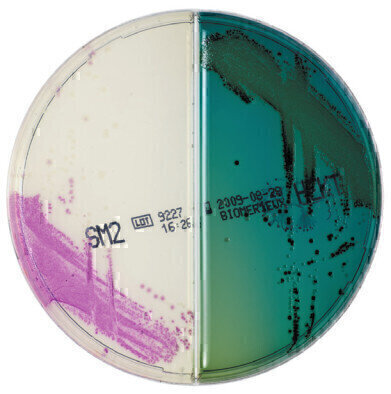
Extra Colour with ChromID Bi-Plates

Laboratory products
Extra Colour with ChromID Bi-Plates
Jun 15 2011
bioMérieux has expanded its pioneering range of chromID chromogenic culture media to offer even greater practicality and performance. The new range of chromID bi-plates combines two media on the same plate, helping clinical laboratories to meet daily culturing and identification challenges more efficiently. Chromogenic media offer enhanced bacterial identification over traditional media through colour differentiation. The intensity and specificity of the colours of chromID media optimise microbial enumeration, making it easy to rapidly identify bacterial colonies. bioMérieux has paired these innovative media with carefully selected, clinically relevant media to offer greater flexibility for laboratory workflows, reducing the number of plates requiring inoculation. The current range includes CPS®/Columbia CNA 5% sheep blood, Mac Conkey/Columbia CNA 5% sheep blood, Strepto B/Columbia CNA 5% sheep blood, Candida/ SGC 2 (Sabouraud gentamicin chloramphenicol 2) and salmonella/Hektoen, with additional plates due later in the year. ChromID bi-plates offer dramatic savings by reducing storage requirements in fridges and incubators, cutting down on waste packaging and streamlining laboratory workflows. Simultaneous reading of two media means results can be obtained more quickly – leading to faster and more objective decision making – reducing the number of plates used and helping to ensure full traceability.
Digital Edition
Lab Asia Dec 2025
December 2025
Chromatography Articles- Cutting-edge sample preparation tools help laboratories to stay ahead of the curveMass Spectrometry & Spectroscopy Articles- Unlocking the complexity of metabolomics: Pushi...
View all digital editions
Events
Jan 21 2026 Tokyo, Japan
Jan 28 2026 Tokyo, Japan
Jan 29 2026 New Delhi, India
Feb 07 2026 Boston, MA, USA
Asia Pharma Expo/Asia Lab Expo
Feb 12 2026 Dhaka, Bangladesh